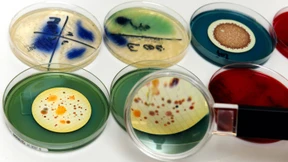
Die Geschichte einer schwierigen Beziehung

Wenn eine Schwangerschaft abrupt endet
Mehr als die Hälfte der Totgeburten galt bisher als unerklärlich. Amerikanische Forscher haben im Erbgut der Kinder Auslöser für das abrupte Ende einer Schwangerschaft entdeckt.

Mehr als die Hälfte der Totgeburten galt bisher als unerklärlich. Amerikanische Forscher haben im Erbgut der Kinder Auslöser für das abrupte Ende einer Schwangerschaft entdeckt.

Tiefsee-Anglerfische stellen möglicherweise die Grundfesten der Immunabwehr in Frage: Um sich zu paaren, verschmelzen sie ihre Körper und verzichten so auf einen wichtigen Teil des Immunsystems.

Die Mitentdeckerin der DNA-Doppelhelix, Rosalind Franklin, war nicht die tragische Heldin und übergangene Frau, für die sie viele halten. Eine Richtigstellung zu ihrem 100. Geburtstag.

Mit Genanalysen will man mehr Licht in die Epoche der Völkerwanderung bringen. Keine leichte Aufgabe. Der Mediävist Patrick Geary zeigt die Grenzen, aber auch die Chancen der genetischen Geschichtsaufarbeitung auf.
Ein Feind und Helfer: Mikroben waren dem Menschen zunächst gefährlicher Gegner – dann nützlicher Begleiter. Wird Sars-CoV-2 unseren Blick auf die Mikroorganismen nun abermals verändern?

Sind schwere Hirnleiden wie Alzheimer oder Chorea Huntington therapierbar, indem man Zellen im Gehirn umprogrammiert? Das Werkzeug dafür jedenfalls nimmt Formen an.

Mitochondrien sind unverzichtbare Bestandteile einer jeden Körperzelle. Gelangt ihre DNA irrtümlich in das Innere der Zelle, kann dies aber eine heftige Immunreaktion auslösen.

Wie wir Menschen besitzen auch Pflanzen und Pilze in einigen „Körperteilen“ ausgereifte Zellapparate, um die Zahl der Mutationen zu minimieren und alt zu werden.

Die zur Vergangenheit arbeitenden Genetiker produzieren revolutionäres Wissen. In Heidelberg hielten sie ihr erstes Welttreffen ab. Wie steht es um die Zusammenarbeit mit Archäologen und Historikern?

„Gene Drive“, das ist alles andere als sanfte Gentechnik. Doch mit ihr könnte man endlich tödliche Malaria zurückdrängen. Die Forscher geben mächtig Gas und müssen dennoch Rückschläge einstecken – trotz einer Wunderwaffe.

Die Megalithkultur war in Europa weit verbreitet. Doch wer waren diese Steinzeitmenschen, und woher kamen sie? Eine genetische Spurensuche in Irland, Schottland und Schweden.

Nicht nur DNA-Spuren, auch Pollen, die an Opfern und Beweisstücken haften, helfen bei der Aufklärung von Verbrechen. Die Palynologin Monika Weber kann schon beim Blick ins Mikroskop häufig den Täter entlarven.

Trotz gefährlicher Strömungen nutzen viele Menschen die „Straße von Gibraltar“ als Übergang von Afrika nach Europa. Analysen prähistorischer DNA zeigen: Schon während der Jungsteinzeit war die Meerenge bei Migranten beliebt.

Für seine Entdeckung, dass Viren Krebs auslösen können, erhielt Harald zur Hausen den Nobelpreis. Nun glaubt er, neue Erreger gefunden zu haben, die unter anderem Darmkrebs auslösen können. Was ist dran an dieser These?

Jahrtausende hatten die Tiere auf Neuseeland eine kleine Welt für sich. Dann machten die Maoris ihnen den Garaus. Fossile DNA liefert neue Einblicke in die einstige Artenvielfalt.

Lange Zeit wurden die Folgen von bakteriellen Infektionen unterschätzt. Inzwischen weiß man, dass Mikroben sogar Krebs auslösen.

Was war den „Sieben von Stillfried“ zugestoßen? War eine Fürstenfamilie umgebracht worden, war es eine Seuche? Ein Bronzezeit-Krimi, der vor Jahrzehnten begann und zu rührenden Thesen über einen ungewöhnlichen Mehrfachtod geführt hat.

Der europäische Gerichtshof hat am Mittwoch über Genscheren entschieden. Müssen uns die Crispr-Pflanzen Sorgen bereiten?

Eine Initiative für die grüne Gentechnik beschäftigte die Nobelpreisträgertagung in Lindau: Es geht vor allem um Welternährung. Wird das einhellige Werben am Ende honoriert?

DNA-Doppelstränge müssen nicht immer linear aufgebaut sein. Der Träger der Erbinformation kann auch verknotet sein. Doch welchen Sinn hat diese kuriose Struktur?

Während der Steinzeit gab es in Nordeuropa und im Mittelmeerraum Einwanderungswellen. Fossiles Erbmaterial liefert neue Einblicke in die Routen der ersten Siedler.

Kommt schon bald die Kehrtwende für die sanfte Biotechnologie? Eine Chinesin zeigt bei ihrem Besuch in Deutschland, wie mit Crispr-Pflanzen die Agrarwende gelingen soll.

Die präzise Feststellung, wann nach einem Gewaltverbrechen der Tod eingetreten ist, kann entscheidend sein. Eintretende zelluläre Veränderungen könnten hierfür eine neue Strategie eröffnen.

Im Koalitionsvertrag finden sich zwar wenig Impulse für die Gentechnik. Über DNA wird in Berlin dennoch viel geredet. Was man so alles in der DNA findet. Eine Glosse.

Kann der Qualm aus den elektrischen Glimmstängeln doch Krebs auslösen? Die Skepsis wächst bei Wissenschaftlern. Eine neue New Yorker Studie entzaubert den vermeintlich harmlosen Nikotindampf.

DNA-Analysen können nicht nur Evolutionsstudien stützen – manchmal entzaubern sie auch hartnäckige Mythen, wie in diesem Fall eines weltbekannten Hochgebirgsbewohners.

Sie gelten als Wunderwaffen und sollen nichts weniger als die Ernährungsprobleme der Welt lösen. Können Genscheren das einlösen? Und wer könnte es verhindern? „Die Debatte“ heute abend im Livestream dreht sich um die neue Grüne Gentechnik.

Wie lassen sich Misserfolge bei künstliche Befruchtungen vermeiden? Um das herauszufinden, haben Forscher nun zum ersten Mal in Großbritannien das Erbgut von Embryonen bearbeitet. Das Verfahren ist umstritten.

Von den einen erwünscht, von den anderen kritisiert: Über die Ausweitung der DNA-Forensik in Deutschland wird heftig diskutiert. Lässt sich mit Hilfe genetischer Spuren überhaupt eine Art Phantombild erstellen?

Leben, wie wir es kennen, kann es auf dem Titan nicht geben. Aber warum nicht welches, das wir uns nicht einmal vorstellen können?

Eizellspenden werden immer beliebter. Doch das „Projekt“ birgt Risiken, die bisher verharmlost wurden. Das Leben von Mutter und Kind steht auf dem Spiel.

Bäume besteigen leichtgemacht: Könnten Frösche Pate stehen für Kletterroboter? Über die Suche nach Vorbildern in den entlegensten Wäldern.

Alter, Augen-, Haar- und Hautfarbe? Das DNA-Profiling soll in Deutschland bei Straftaten ausgeweitet werden. Der Gesetzentwurf stößt auf Kritik.

Wie geht ein zwanzig Kilometer langer Faden knotenfrei in einen Tennisball? Das Leben löst diese Aufgabe im Kleinstmaßstab millionenfach in unserem Körper. Jetzt haben Forscher die Faltkunst sichtbar gemacht.

Alle Daten der Welt in einem Kilo verpackt, fehlerfrei gesichert bis ans Ende der Tage? Mit Chips bräuchte es dazu nicht nur eines Energiewunders. Zwei Biologen haben einen „DNA-Brunnen“ programmiert, der die Erbsubstanz als Datenspeicher sexy macht.

Der Schöpfer hat längst Konkurrenz, und die holt jetzt mächtig auf: Chemiker haben in Bakterienkulturen das Lebensalphabet von vier auf sechs Buchstaben erweitert. Die Kunstkeime gedeihen prächtig.